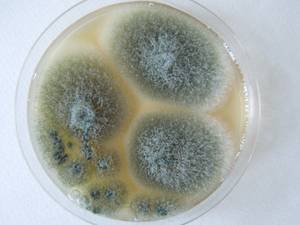
MSU_FS-02585 01, Район Кон Плонг (Kon Plông district), Провинция Контум (Kon Tum province) (Вьетнам)

Всего записей: 3
Всего страниц: 1
По организмам

- ID образца
- 0000002675514
- Вид
- Aspergillus fumigatus
- Штамм
- F-294
- Место сбора
- Земля Франца-Иосифа, Архангельская область (Россия)
- Топоним
- остров Алджер
- ID образца
- 0000000905628
- Вид
- Aspergillus fumigatus
- Штамм
- MSU_FS-02585
- Место сбора
- Район Кон Плонг (Kon Plông district), Провинция Контум (Kon Tum province) (Вьетнам)
- Топоним
- Манг Кань (Măng Cành commune)

- ID образца
- 0000000905124
- Вид
- Aspergillus fumigatus
- Штамм
- MSU_FS-02160
- Место сбора
- Район Лак (Lắk district), Провинция Даклак (Đắk Lắk province) (Вьетнам)
- Топоним
- Бонг Кранг (Bông Krang)